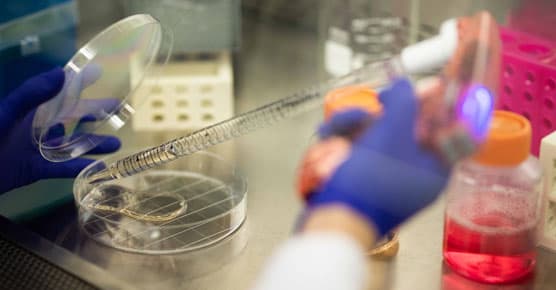

About the Comprehensive Cancer Center

At the Forefront of Cancer Care & Discovery
At the University of Chicago Medicine Comprehensive Cancer Center, we know a cancer diagnosis can be life changing. We put minds at ease by seeing new patients quickly — and helping them understand their disease and treatment options.
With more than 200 cancer specialists, innovative treatments, leading-edge research and clinical trials not available elsewhere, we're leading the way in the prevention, diagnosis and treatment of cancer.
We are proud to be one of two NCI-designated comprehensive cancer centers in Illinois. The prestigious American College of Surgeons' Commission on Cancer has recognized our main campus location with its top accreditation and has designated UChicago Medicine Ingalls Memorial with its Outstanding Achievement Award, the highest award a community hospital can receive for excellence in cancer care.
Our scientists study disease at the molecular level and clinical researchers apply the knowledge discovered in our laboratories to create and test promising new treatments and procedures. Our experts bring patients hope as they test new therapies.
We also specialize in cancer control, prevention and population research while implementing new approaches to screening and prevention. We partner with our community by teaching state-of-the-art diagnostics to local physicians. And we work to encourage our neighbors to adopt a healthy lifestyle that includes cancer screenings. A key part of our mission is community research to eliminate health disparities among ethnic and social groups.

Mission & Values
Learn about the many ways we're working to prevent and reduce cancer's devastating effects through collaborative research and superior patient care.

What Does It Mean to Be an NCI-Designated Comprehensive Cancer Center?
It's the gold standard for cancer programs and is bestowed upon the nation’s top cancer centers in recognition of their innovative research and leading-edge treatments.

Our Leadership
Meet UChicago Medicine Comprehensive Cancer Center leadership.
Cancer Research & Clinical Trials
Our physician and scientists are committed to unlocking the mysteries of cancer and are behind some of the most important advances in cancer therapy and research.

Cancer Patient Demographics
View demographic information about our cancer patients, including cancer types, race/ethnicity and geographic data.

Cancer News & Publications
Read Comprehensive Cancer Center publications, including newsletters and annual reports.
Convenient Locations for Cancer Care
Request an Appointment for Cancer Care
We are currently experiencing a high volume of inquiries, leading to delayed response times. For faster assistance, please call 1-855-702-8222 to schedule your appointment.
If you have symptoms of an urgent nature, please call your doctor or go to the emergency room immediately.
For Referring Physicians
To refer a patient for cancer care, please call UCM Physician Connect at 1-800-824-2282.
* Indicates required field


